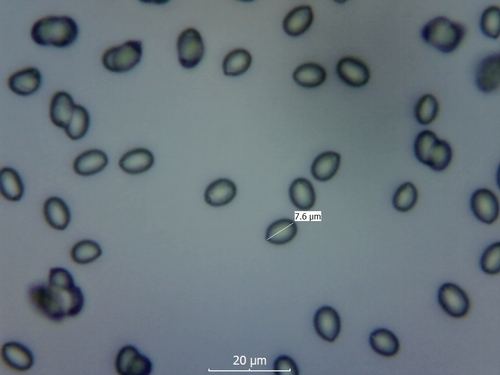

Der Dattelbrauner Ellerling (Cuphophyllus colemannianus) ist ein Pilz mit dem Speisewert ausgezeichnet. Die Hauptsaison erstreckt sich von September bis Dezember. Er wächst bevorzugt auf Boden, Wiese. Ein charakteristisches Merkmal ist seine Hygrophanität (Änderung der Hutfarbe bei Nässe).
Der 2–6 cm breite Hut ist weiß-braun-orange gefärbt. Die Form ist meist kegelförmig, schirmförmig. Er ist hygrophan (Die Hutfarbe ändert sich bei Feuchtigkeit).
Die Unterseite zeigt Farben von weiß/braun/orange/grau/blau. Sie sind angewachsen, herablaufend.
Der Stiel ist weiß-braun. Besondere Merkmale: hohl.
Er hat einen milden Geschmack. Das Sporenpulver ist weiß.
